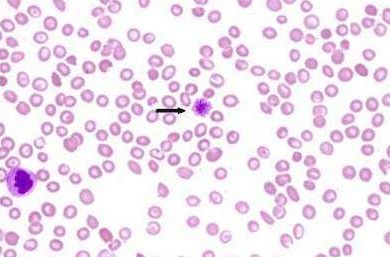
640 (8).jpg

最近
很多人小时候都吃过的“退烧神药”
“安乃近”
又被推上了风口浪尖
据介绍,这种药被30多个国家拉进黑名单,原因是该药副作用发生概率高,二则副作用反应大,严重的可休克、致死。

消息一出,引起众多网友的恐慌
那么,这种药到底还能不能用?
事实是怎样的?
今天,我们就为大家科普一下!
安乃近是一种什么药?
安乃近是1920年由德国HoechstAG公司合成的一种解热镇痛药,属非甾体抗炎药,具有解热、镇痛及抗炎抗风湿作用。1922年上市后,在世界各国作为非处方“退烧神药”风靡一时,广泛使用了半个世纪。

安乃近现在的使用现状?
美国禁用40年,30多个国家列入黑名单:1974年瑞典撤销了安乃近的上市许可。1977年,美国正式禁用安乃近,并将该药品从美国市场上撤出,多种剂型的临床应用被叫停。随后,澳大利亚、日本、伊朗等30多个国家明令禁用或限用安乃近。

对于“安乃近”巨大的副作用案例,我国于1982年发布了《关于公布淘汰127种药品的通知》淘汰了“复方安乃近片剂”。《中国循证儿科》学术期刊2008年的指南,明确指出“安乃近可致中性粒细胞减少,儿童不推荐应用”。
安乃近有哪些副作用?
1对血液系统影响
较长时间使用可引起粒细胞减少,发生率约1.1%,急性起病,重者有致命危险,亦可引起血小板减少性紫癜,严重者可有再生障碍性贫血。
2局部反应
注射部位可有红肿、疼痛,数天后才消退;有的患者呈毒血症症状,皮下出血点,或有紫黑色脓液,数月后才能痊愈。

3
对肝肾功能影响
可出现药物性肝损伤,有的可能出现急性肝肾衰竭,危及生命。
4过敏反应
过敏性皮疹或药热、荨麻疹、严重者可有剥脱性皮炎、大疱性表皮松解症导致死亡。个别病例可发生过敏性休克,甚至导致死亡。
儿童应如何科学退烧?
高热易引起小儿惊厥,当家长发现孩子发热时应予以重视,体温持续不退应积极就诊,一般在超过38.5℃的体温才开始用药。
0-3岁以内的婴幼儿体温超过38.5℃,3岁以上的儿童体温超过38℃,可同时采用冰袋、冷敷等物理降温疗法。

目前,世界卫生组织(WHO)对全球儿童推荐、副作用小的退烧药只有对乙酰氨基酚和布洛芬两种。对乙酰氨基酚可用于2~3个月以上的宝宝,布洛芬可用于 6 个月以上的宝宝。

退烧药不要和碱性药物同时服用,否则会降低疗效。忌长期服用退烧药,一般疗程不超过一周。不要同时使用两种以上的退烧药。
在发热期间出汗增多,机体水分消耗增加,家长应给孩子多喝开水,有利于药物吸收和排泄。
饮食的选择可遵循由稀到干和清淡的原则。
正确、合理地用药可治病
反之则可能致病哦!























